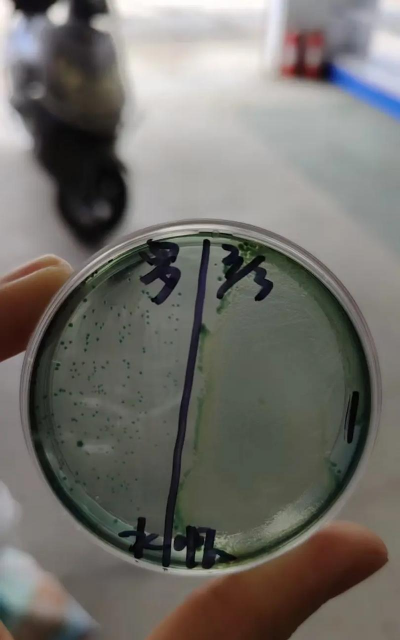

热门推荐
小龙虾养殖提质增效技术措施
河蟹养殖如何给螃蟹保肝护肠?料里加入它,螃蟹长得快少病害
虾类的高寿命损失:双重环境因素引发大规模死亡
淡水养殖对虾的经验分享
对虾养殖,拌料常常无效!就是你不注意这8点细节!
高温季节对虾养殖常见问题及防控要点
对虾工厂化健康养殖技术
对虾养殖指南:从入门到精通的实操经验
畜牧热门
养殖热门
花卉热门
园林热门
噬弧菌南美白对虾
“噬弧菌”和“南美白对虾”是两个不同的概念,但它们在水产养殖中可能有交集。以下是对这两个术语的解释以及它们之间的关系:

一、噬弧菌(Vibrio)
1. 定义:
噬弧菌是一类革兰氏阴性细菌,属于弧菌属(*Vibrio*),广泛存在于海水、淡水和土壤中。其中一些种类是致病菌,可以引起人类和水生生物的疾病。
2. 常见种类:
*Vibrio parahaemolyticus*:可引起人类食物中毒。
*Vibrio vulnificus*:可引起严重感染,尤其是对免疫力低下者。
*Vibrio alginolyticus*:常与水产养殖中的疾病有关。
*Vibrio harveyi*:常见于对虾养殖中,可引起对虾疾病。
3. 在水产养殖中的影响:
噬弧菌是南美白对虾(*Litopenaeus vannamei*)养殖中最常见的病原菌之一。
可引发对虾的“红腿病”、“肝胰腺坏死症”等疾病,导致大量死亡,造成经济损失。
二、南美白对虾(Litopenaeus vannamei)
1. 简介:
南美白对虾是一种广泛养殖的经济虾类,原产于东太平洋沿岸,现已被全球广泛养殖,尤其在中国、东南亚、南美等地。
2. 养殖特点:
生长快、适应性强、抗病能力较强。
是中国水产养殖业的重要经济物种。
3. 常见病害:
噬弧菌病(如红腿病、肝胰腺坏死)
对虾杆状病毒(MBV)
水霉病
肠道疾病
三、噬弧菌与南美白对虾的关系
在南美白对虾的养殖过程中,噬弧菌是主要的病原微生物之一,尤其是在水质管理不当、密度高、饲料质量差等情况下更容易爆发。
常见症状包括:
虾体发红(红腿病)
肝胰腺变色或坏死
活动力下降
死亡率升高
防控措施:
改善水质(定期换水、控制氨氮、亚硝酸盐等指标)
使用益生菌(如乳酸菌、芽孢杆菌)抑制有害菌
合理投喂,避免过量投喂导致水质恶化
使用抗生素(需谨慎,避免耐药性)
接种疫苗(部分国家已开发相关疫苗)

四、
| 项目 | 内容 |
| 噬弧菌 | 弧菌属细菌,是南美白对虾的主要病原菌之一 |
| 南美白对虾 | 重要的水产养殖品种,易受噬弧菌感染 |
| 疾病 | 红腿病、肝胰腺坏死等 |
| 防控 | 水质管理、益生菌、合理投喂、抗生素使用等 |
如果你是在问“噬弧菌是否能用来防治南美白对虾的病害”,那答案是:噬弧菌本身是病原菌,不能用于防治,但某些噬菌体(bacteriophage)可以专门针对噬弧菌进行控制,这是近年来研究的一个方向。
如果你需要更具体的养殖建议或病害防控方案,欢迎继续提问!
猜你喜欢内容
-
南美对虾中后期脱壳
南美对虾(主要指凡纳滨对虾,*Litopenaeus vannamei*)在养殖过程中,尤其是中后...
-
养殖50天对虾多大
对虾(如凡纳滨对虾,即南美白对虾)在养殖50天后的体长会受到多种因素的影响,包...
-
低聚糖在对虾养殖
低聚糖(Oligosaccharides)在对虾养殖中被广泛用作饲料添加剂,具有多种功能,能...
-
日本对虾养殖厂
日本对虾(学名:*Penaeus japonicus*),又称日本明虾、日本虎虾,是一种广泛养殖...
-
对虾白便灵价格
“对虾白便灵”可能是指用于防治对虾(如南美白对虾)白便病的药物或添加剂。白便...
-
南美白对虾外壳发白
南美白对虾(Litopenaeus vannamei)在养殖过程中,如果出现外壳发白的现象,通常...
-
对虾肝脏保护膜
“对虾肝脏保护膜”这个术语可能是指在对虾(如凡纳滨对虾、中国对虾等)养殖过程...
-
南美白对虾春季养殖
南美白对虾(*Litopenaeus vannamei*)是目前全球养殖最广泛的对虾种类之一,因其...
-
石灰对虾有影响吗
石灰(通常指生石灰,即氧化钙,CaO)在水产养殖中有时会被使用,但对虾是有影响的...
-
白对虾苗脱壳不遂
白对虾苗在养殖过程中出现脱壳不遂(也叫“蜕壳困难”)是常见的问题,尤其是在幼...
农业知识▪优秀内容



